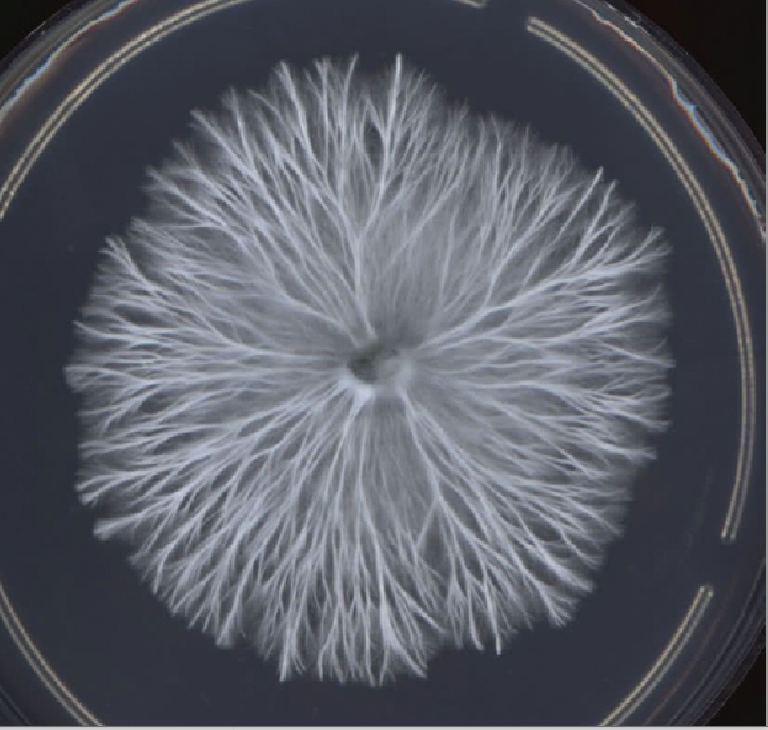

MYCELIUM
Med ekstreme temperaturudsving, tørke, oversvømmelser, destabiliserede økosystemer og eksponentiel nedgang i biodiversitet og naturressourcer, er det erkendt, at forholdet mellem menneske, natur og kultur har forskubbet sig i sådan en grad, at der er tale om et reelt skifte fra den Holocæne til den antropocæne tidsalder. En tidsalder, hvor det er menneskelige handlinger, der er afgørende for, hvordan Jordens fysiske og levende systemer udvikler sig de næste mange tusind år. I dette ligger således også erkendelsen af omfanget af vores ansvar i forhold til at sikre en levedygtig jord for vores børn og efterfølgende generationer. Med en europæisk byggebranche, der står sig for næsten 40% af den årlige globale CO2-emissioner. Tal fra Green Building Council viser, at for nybyggeri i Danmark kan ca. 80% af klimaaftrykket over en bygnings levetid henvises til materialer. Derudover står byggematerialer for 13% af det genererede affald i Danmark. Som Dansk statusborger er vi ansvarlige for et overforbrug i et omfang, hvor vi forbruger 4 gange af planetens tilgængelige ressourcer fordelt pr. global indbygger. Det er tydeligt, at der er akut brug for nye praksisser.
Der er derfor behov for at bygge- og arkitekturpraksis skaber plads til nye innovative materialer og et nyt regenerativt designparadigme, der sætter spørgsmålstegn ved vores nuværende design-, fremstillings- og konstruktionsmetoder. Et paradigme der sigter mod nul påvirkning gennem regenerativ og respektfuld bygning design. Gennem de seneste århundreder er vi i stigende grad blevet separeret fra naturen. En adskillelse, der som har gjort uoprettelige skader på naturen og på klimaet. Samtidig peger forskningen i stigende grad på betydningen af de komplekse sammenhænge koblet til vores relationer til naturen, for vores fysiske og mentale sundhed og i sidste ende for vores overlevelse. Det er derfor på tide, at ændre vores måde at bo og leve med naturen, hvis vi vil sikre fremtidige generationer. Dette kræver, at vi gentænker og genopdager betydningen af en nær relation mellem menneske og natur og forstår nødvendigheden af at arbejde med respekt og forståelse for naturens processer og systemer. Vores ambition med denne udstilling er at øge bevidstheden om at det er muligt, at skabe et gensidigt genopbyggeligt forhold mellem menneske og naturens systemer med regenerative løsninger, inspireret af naturens processer.

Fremstillingsproces
Svampe er verdens største genbrugende organisme. Uden tilførsel af energi tilføres svampesporer bioaffald. Sporere vokser og omdanner bioaffaldet til et let, isolerende, brand, fugt- og brandafvisende biomateriale. Materialet er formbart og egner sig, efter opvarmning og udtørring, til varmeisolering, lyddæmpning og som et stærkt trykoptagende strukturelt element. I en proces hvor bioaffaldet neddeles fint og iført komplekse udskårne forme, kan gros materialer i inhomogen geometri for skulpturel og organisk formgivning og detaljering. Ved at kombinere det naturlige materiale med moderne konstruktionsteori og digital fabrikation effektiviseres dette, og der opnås mulighed for materialebesparelse, hvor man ikke længere er begrænset til den rationelle firkantede form, men en statisk optimeret form, hvor materialet primært placeres hvor de indre kræfter løber. Som en del af den konstruktive udformning øges diameteren af toppen af søjlen. Herved angribes ovenliggende konstruktioner med en større overflade og derved mindre spænding. Efterhånden som lasten føres ned gennem konstruktionen, koncentreres lasten og spændingen i søjlen øges. Udformningen kan sidestilles med en klassisk kapitæl, hvor et ”hoved” på toppen af en søjle møder den ovenliggende bjælke- og dækkonstruktion. Objektets komplekse overdel groes i 4 ens dele, i forme udskåret ved brug af en industriel 5-akset robotarm. Soklen udgøres af 2 simple cylinderforme, der kan justeres i størrelsen, så konstruktionen tilpasses rummet, og spænder fra gulv til loft. Overdelen er produceret opdelt af hensyn til transport ind og ud af udstillingsrummet. Konstruktionen samles og fæstnes til loftet med brug af hhv. tøndebånd og en cirkulær plade der monteres på træspærerne i Biennalens udstillingsrum. Det er imidlertid visionen, at myceliumsøjler groes i én del, da det sammenhængende tværsnit hhv. vil give maksimal styrke, fjerne behov for sekundære samlinger samt muliggøre at søjlens top kan fæstnes ved at gro sammen med et biologisk etagedæk som eksempelvis træbaserede CLT-elementer.






